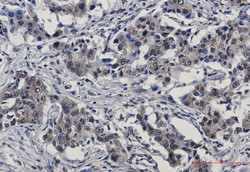
IRF3 Antibody in Immunohistochemistry (Paraffin) (IHC (P))

Search
Abnova
IRF3 Recombinant Rabbit Monoclonal Antibody
{{$productOrderCtrl.translations['antibody.pdp.commerceCard.promotion.promotions']}}
{{$productOrderCtrl.translations['antibody.pdp.commerceCard.promotion.viewpromo']}}
{{$productOrderCtrl.translations['antibody.pdp.commerceCard.promotion.promocode']}}: {{promo.promoCode}} {{promo.promoTitle}} {{promo.promoDescription}}. {{$productOrderCtrl.translations['antibody.pdp.commerceCard.promotion.learnmore']}}
产品信息
RAB01424
种属反应
宿主/亚型
Expression System
分类
类型
抗原
偶联物
形式
纯化类型
保存液
内含物
保存条件
运输条件
靶标信息
IFR3 (interferon regulatory factor 3) is a key transcriptional regulator of type I interferon (IFN)-dependent immune responses. It plays a critical role in the innate immune response against DNA and RNA viruses. IFR3 regulates the transcription of type I IFN genes (IFN-alpha and IFN-beta) and IFN-stimulated genes (ISG) by binding to an interferon-stimulated response element (ISRE) in their promoters. It acts as a more potent activator of the IFN-beta gene than the IFN-alpha gene and plays a critical role in both the early and late phases of the IFNA/B gene induction. IFR3 is found in an inactive form in the cytoplasm of uninfected cells and following viral infection, double-stranded RNA, or toll-like receptor signaling. It is phosphorylated by IKBKE and TBK1 kinases. This induces a conformational change, leading to its dimerization and nuclear localization and association with CREB binding protein to form dsRNA-activated factor 1 (DRAF1), a complex which activates the transcription of the type I IFN and ISG genes. Mutations in the gene can result in encephalopathy, acute, infection-induced, herpes-specific 7.
仅用于科研。不用于诊断过程。未经明确授权不得转售。
篇参考文献 (0)
生物信息学
蛋白别名: Interferon regulatory factor 3; IRF-3; IRF-3a; IRF-3b; IRF-3c; IRF-3d; IRF-3e; IRF-3f; IRF3 (phospho S386); IRF3 (pS386); IRF3 (pSer386); IRF3 phospho; IRF3 phospho S386; IRF3 phospho Ser386; phospho IRF3; unnamed protein product
基因别名: IIAE7; IRF3
UniProt ID: (Human) Q14653
Entrez Gene ID: (Human) 3661